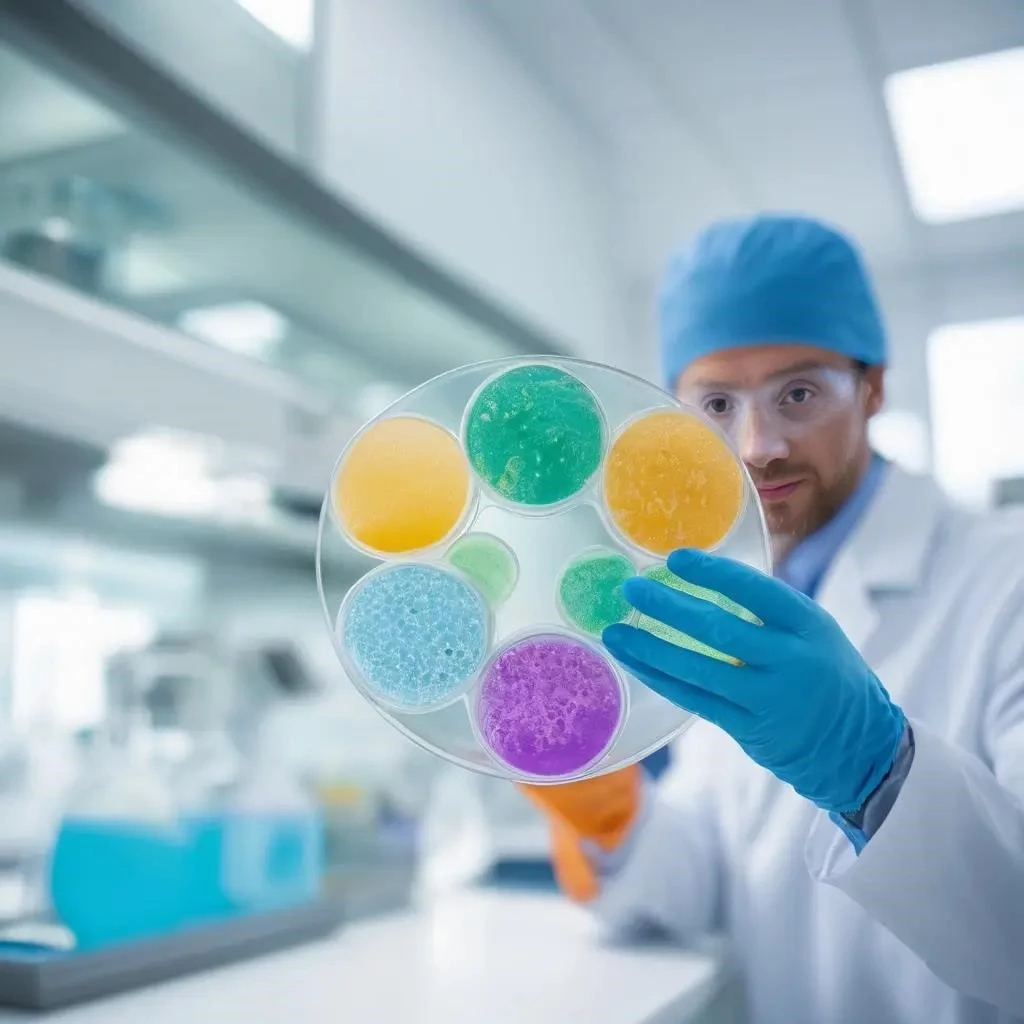

Бактериологический посев из зева позволяет определить точный состав микрофлоры ротоглотки и выявить возбудителей воспалительного процесса. Врач назначает это исследование при частых ангинах, хроническом тонзиллите или подозрении на опасные инфекции вроде дифтерии. Процедура помогает отличить бактериальную агрессию от вирусного поражения, что определяет тактику дальнейшего лечения. В ходе анализа специалисты используют селективные питательные среды для выращивания колоний микроорганизмов. Лабораторная диагностика исключает необоснованный прием антибиотиков и предотвращает переход болезни в хроническую форму. Результаты посева содержат информацию о количестве бактерий и их чувствительности к конкретным антимикробным препаратам. Своевременный мазок помогает избежать серьезных осложнений на сердечную мышцу и суставы. Исследование считается золотым стандартом в отоларингологии для верификации диагноза. Правильная интерпретация данных позволяет составить эффективную схему терапии за один визит к врачу. Пациент получает на руки подробный протокол с указанием всех обнаруженных микробов;
Бактериологическое исследование мазка из ротоглотки считается фундаментальным методом в современной отоларингологии. Специалист назначает процедуру, когда стандартные методы осмотра не дают полной картины этиологии заболевания. Мазок позволяет выявить скрытых возбудителей, которые годами паразитируют на слизистых оболочках, вызывая вялотекущее воспаление. Лаборант переносит биоматериал на специальные чашки Петри со специфическим питательным субстратом. В условиях термостата микробы начинают активно делиться, формируя видимые колонии в течение нескольких суток. Каждая колония имеет свои уникальные морфологические признаки, позволяющие лаборанту точно определить вид агрессора. Этот процесс исключает диагностические ошибки и помогает врачу подобрать лекарство строго «в цель». Использование современных тест-систем сокращает время ожидания и значительно повышает точность идентификации штаммов. Своевременный анализ предотвращает системное поражение организма токсинами бактерий. Пациент получает четкое понимание причин своего состояния без лишних догадок и ненужных манипуляций. Диагностика в лаборатории сводит к минимуму риск развития резистентности у микроорганизмов. Врач опирается на твердые лабораторные факты, а не на субъективные предположения. Грамотный подход к верификации диагноза экономит время и бюджет больного. Посев остается незаменимым инструментом в борьбе с рецидивирующими инфекциями верхних дыхательных путей.
Ситуации, требующие микробиологического подтверждения
- Рецидивирующие боли в горле, которые не поддаются стандартному лечению антисептиками.
- Подозрение на наличие специфических инфекций, требующих экстренных карантинных мер.
- Оценка эффективности проведенного курса антибактериальной терапии через четырнадцать дней.
- Профилактическое обследование перед плановыми хирургическими операциями на носоглотке.
- Длительный субфебрилитет неясного происхождения, сохраняющийся более одной недели.
- Контакт с больными тяжелыми формами ангины в бытовых условиях или на работе.
- Скрининг при планировании беременности для исключения носительства опасных штаммов.
- Появление специфического налета на миндалинах, не характерного для обычного ОРВИ.
Лабораторная диагностика играет ключевую роль в дифференциации различных патологических состояний. Вирусные инфекции часто имитируют бактериальное поражение, что нередко приводит к неоправданному использованию мощных препаратов. Бакпосев расставляет все точки над «и», показывая реальную биологическую угрозу. Врач видит не только название микроба, но и его точное количество, выраженное в специальных единицах. Это позволяет отличить простое носительство от активной стадии патологического процесса. Если титр превышает норму, требуется немедленное вмешательство для защиты внутренних органов и систем. Особенно опасен бета-гемолитический стрептококк, который способен атаковать ткани сердца, почек и суставов. Без адекватного лечения обычная ангина может перерасти в ревматизм или серьезный гломерулонефрит. Исследование чувствительности к антибиотикам избавляет пациента от приема заведомо неэффективных химических средств. Таким образом, анализ экономит внутренние ресурсы организма, направляя терапию в строго заданное русло. Результаты бакпосева позволяют избежать перехода острой формы болезни в хроническую патологию.
Сравнение клинической картины и подходов
| Критерий оценки | Вирусная природа | Бактериальная природа |
|---|---|---|
| Начало болезни | Острое, с насморком и кашлем | Резкое, часто без кашля |
| Вид миндалин | Яркое покраснение, отечность | Гнойные пробки, плотный налет |
| Лимфоузлы | Умеренное увеличение | Сильная болезненность и отек |
| Тактика лечения | Симптоматическая помощь | Антибактериальные препараты |
Рекомендации по тактике действий
Специалисты настоятельно рекомендуют дождаться полных результатов посева перед сменой антибиотика, если состояние пациента остается стабильным. Частое бесконтрольное использование полосканий с антисептиками непосредственно перед визитом в лабораторию может «смазать» картину и дать ложноотрицательный результат. Важно помнить, что обнаружение стафилококка в низком титре у здорового человека не требует агрессивного лечения, так как он является частью нормальной микрофлоры. Основное внимание следует уделять именно патогенным штаммам, которые вызывают яркую клиническую симптоматику. После завершения курса терапии полезно сдать повторный мазок для подтверждения полной эрадикации возбудителя. Это исключит переход инфекции в спящий режим и предотвратит будущие рецидивы. Поддержание местного иммунитета слизистых оболочек поможет избежать повторного заселения патогенами после выздоровления. Правильная интерпретация данных антибиотикограммы позволяет врачу выбрать препарат с наименьшим количеством побочных эффектов для конкретного человека.
Информационная справка для пациентов
Почему анализ готовится несколько дней? Бактериям необходимо время для роста на питательной среде до формирования колоний, которые можно точно идентифицировать.
Можно ли сдавать мазок во время приема антибиотиков? Нет, лекарственные препараты подавляют рост микрофлоры, что делает исследование неинформативным и искажает реальную картину.
Что означает фраза «рост не обнаружен»? Это говорит о том, что в исследуемом материале отсутствуют патогенные бактерии или их количество ничтожно мало для развития болезни.
Нужно ли лечить носительство золотистого стафилококка? Решение принимает врач на основании жалоб; при полном отсутствии симптомов специфическое лечение обычно не требуется.